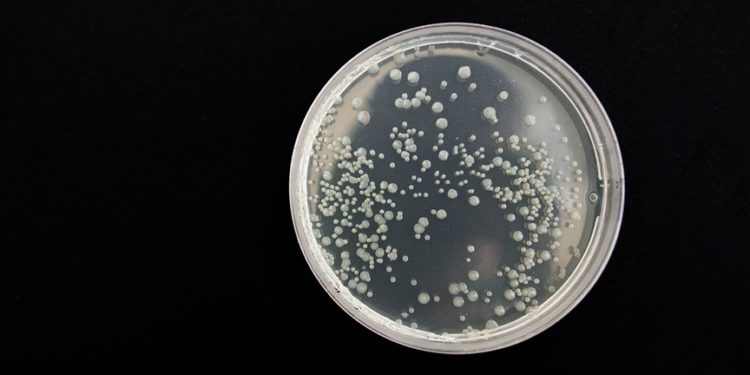
Bazı ölümcül bakteriler "vampir gibi" insan kanından besleniyor

ABD merkezli yapılan bir araştırma, “bakteriyel vampirizm” adı altında bazı ölümcül bakterilerin insan kanından beslendiği sonucuna ulaştı.
Bazı ölümcül bakteriler "vampir gibi" insan kanından besleniyor
A
A
0
Görüntülenme
- Trend
- Yorumlar
- Yeni
Browse by Category
- ! Без рубрики
- – 40
- – 519
- 1 xBet Android iOS indir Tətbiq – 489
- 1win Azerbajany
- 1Win Azerbaycan : 1 Win bukmeker kontoru – 698
- 1Win Azerbaycan Giriş login və Qeydiyyat yukle – 19
- 1WIN Bonus
- 1Win Brasil
- 1xbet apk
- 1xbet Argentina
- 1xbet Azerbajan
- 1xbet Brazil
- 1xbet giriş
- 1XBET Mobile APK Smartfon proqramını yükləyin – 77
- 733
- adult dating sites
- After Getting Married Checklist
- AI News
- Artificial intelligence
- asian dating
- asian mail order brides
- AZ Most BET
- Azerbajany Mostbet
- Azərbaycanda MostBet bukmeker kontorunun icmalı – 307
- Azərbaycanda MostBet bukmeker kontorunun icmalı – 912
- Azərbaycanda MostBet bukmeker kontorunun icmalı 161
- b1bet apostas
- Bahis siteleri
- bahis sitesi
- Best Asian Wives
- best colombian dating sites
- Best Mail Order Bride Service
- Best Nationality Man To Datehttps://3.bp.blogspot.com/-kBknlnppsDo/VogAaAUQObI/AAAAAAAAGIQ/GwgzMkHTbi4/s400/beautiful-bbw-13_mini.jpg|loving someone long distance
- Best Website To Find Women
- betboo
- Betmotion brazil
- Bitcoin News
- blog
- Bonus bei VulkanVegasCasino DE, Login, Anmeldung 2023 – 953
- Bookkeeping
- buy a wife online
- canli bahis
- Casino
- casinomaxi
- chilean women
- Codere AR
- codere mexico
- Cryptocurrency exchange
- Cryptocurrency News
- das beste Casino Deutschlands – 113
- das beste Casino Deutschlands 754
- Dating
- Dating A Foreigner
- dating critic
- Dating Foreign Women
- dating over 40
- dating sites reviews
- Dating Someone From A Different Country
- Download Firmware
- Download ROMs
- Education
- Ekonomi
- extrabet
- Fall In Love With Someone You Don't Share A Common Language
- filipino dating sites
- find a wife online
- FinTech
- Firmware ROMs
- Flash Files
- Forex Trading
- Gündem
- hookup sites
- How Much Is A Mail Order Bride
- How To Date Someone Internationally
- How To Have A Small Wedding
- India Mostbet
- international dating
- IT Вакансії
- IT Образование
- Kommunal az : Kommunal ödənişlər – 804
- leovegas finland
- LeoVegas Sweden
- mail brides online
- mail order bride
- mail order bride cost
- mail order bride online
- Mail Order Bride Websites
- mail order brides
- mail order brides online
- mail order wives
- Marriage Certificate Requirements
- marsbahis
- meet latin brides
- Meet Single Women
- mostbet apk
- Mostbet AZ
- mostbet az 90
- MostBet AZ Most Bet Casino Qeydiyyat, Yukle Android App 900
- mostbet azerbaijan
- Mostbet Azerbaycan
- Mostbet Casino
- Mostbet Casino TR nasıl giriş yapılır, online casino oyunları ve slotlar, kullanıcılar için mevduat yöntemleri 700
- mostbet giriş
- Mostbet in Russia
- Mostbet in Turkey
- Mostbet India
- Mostbet kazinosu
- mostbet kirish
- Mostbet kumarhanesi
- mostbet ozbekistonda
- mostbet royxatga olish
- mostbet UZ
- Mostbet Uzbekistan
- Mostbet официальный сайт: личный кабинет Мостбет, регистрация – 544
- New
- Online Dating
- online dating services
- online dating sites
- overseas wife dating
- Oynamaq Pin Up Azərbaycan: rəsmi saytın nəzərdən keçirilməsi – 110
- pagbet brazil
- Pin Up Casino Online Slots Review – 96
- Pin-Up Casino kontorunun təsviri, pin up az – 156
- Pin-Up Casino kontorunun təsviri, pin up az – 354
- PinUp apk
- PinUp AZ
- PinUp Azerbaijan
- PinUp Brazil
- PinUp Kazakhstan
- PinUp Russian
- PinUp Turkey
- playbison
- polish dating sites
- pusulabet
- Python Development
- Sağlık
- sex chat
- Should A Guy Pay On The First Date
- Siyaset
- Sober living
- Software development
- Spor
- Stock Firmware
- Successful Interracial Marriages
- Suchergebnisse Für: "vulkan Vegas Casino Review Open️top883 Com$limitadong Regalo! Mag Register Para Makakuha Ng P50 May 50% Cashback Sayong " – 525
- sugar daddy sites
- thai women dating
- top chinese dating
- top dating reviews
- top dating sites
- top mail order brides
- Top Online Casino Jetzt Für Einsteiger Vulkan Vegas Deutschland! – 955
- Ukrainian Women Characteristics
- UZ Most bet
- vietnamese women
- Vulkan Vegas Bonus im Juli 2023: 200 % bis zu 1 000,00 EUR 756
- vulkan vegas DE
- vulkan vegas DE login
- Vulkan Vegas Poland
- Vulkan Vegas: Tauchen Sie ein in eine Welt voller Spielelust – 903
- VulkanVegas Login: Odkryj niesamowity świat hazardu 213
- VulkanVegas Poland
- Welche Online Partnervermittlung Ist Die Beste
- What Are Russian Women Like
- What Makes A Woman Fall In Love
- Where To Meet Single Women
- Wybieraj Legalne Kasyno Internetowego – 696
- Yaşam
- YOUWIN 一 Hepsibahis güncel giriş adresi Youwin – 333
- Выиграй 9000000 сум в букмекерской конторе Мостбет – 391
- Криптовалюты
- Мобильная версия БК Мостбет официальный сайт Mostbet для смартфонов и планшетов 328
- Новости Криптовалют
- Официальный сайт Мостбет Ставки на спорт Mostbet – 693
- Приложение Mostbet UZ скачать на Андроид APK, Айфон IOS – 282
- Сегодня, 1 июля началась онлайн-регистрация документов соискателей в магистратуру – 907
- Финтех
- Форекс Брокеры
- Форекс Обучение
- Форекс партнерская программа